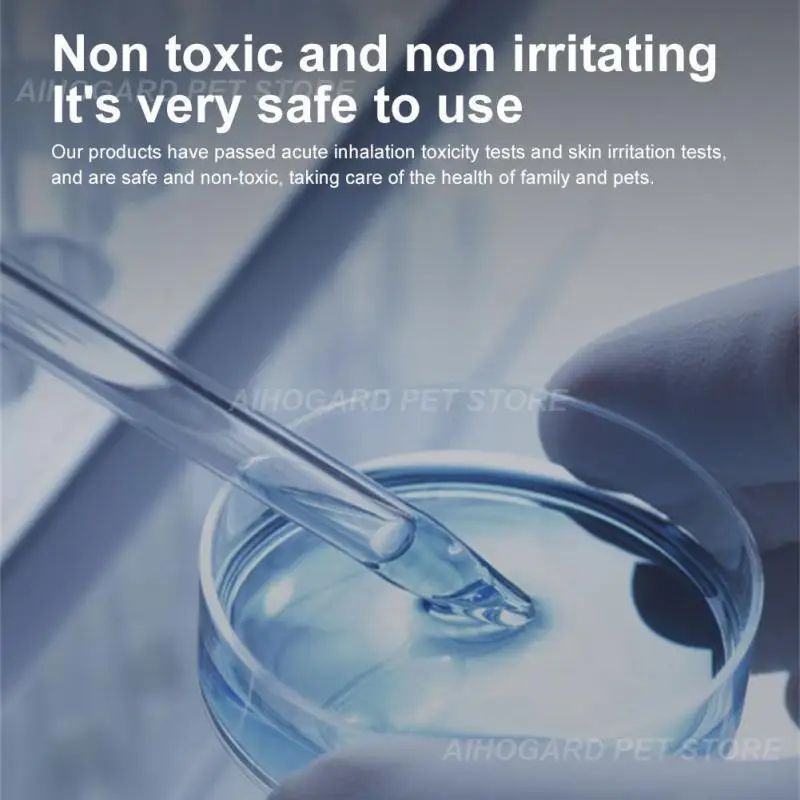
thumb

1/2 шт. дезодорирующий куб N50 для PETKIT PURA MAX кошачий наполнитель Автоматическая лопатка принадлежности для кошек комплект для собак и кошек pura max
Пользователи также просматривали

$6.08
Brand New VK-162 Laptop Usb Gps Navigation Module GPS Navigation Support For All Series Win System Drive
aliexpress.com
$6.96
10PCS Plush Hangers for Anti Slip, Seamless, Dry and Wet Dual-purpose Clothing Store, Home and Home Storage
aliexpress.com
$4.17
39MM Piston Ring Pin Circlips Set For Honda GX35 GX35NT HHT35S UMK35 Brush Cutter Engine 13101-Z0Z-010, 13101-Z0Z-000 Replaces
aliexpress.com
$40.31
Car Front Headlights Fog Light Lamp 31111182 31111183 For VOLVO XC90 2002-2013 Driving Foglights Without Light Bulb
aliexpress.com
$13.94
Новинка 2024, Женский пуловер с принтом в виде розового тигра, толстовки с круглым вырезом, свободные повседневные топы, модные пуловеры в стиле Инди для весны и осени, NASY0008
aliexpress.ru
$36.26
18 см, аниме-трансформер Pangu, модели игрушек, подвижная модель из ПВХ для детей, коллекционные игрушки, подарок для взрослых
aliexpress.ru
$7.96
Симпатичная плюшевая кукла Sanrio Kuromi Melody Jade Gui Dog, декоративная кукла, подушка, Подарочная игрушка
aliexpress.ru
$21.00
Motorcycle For Honda VT125 VT 125 shadow Accessories Radiator Grille Cover Guard Protection Protetor 1999-2007 2006 2005 2004
aliexpress.ru
$11.16
Ткань для тафтинга, нескользящая ткань для тафтинга, ткань для тафтинга с узором цветущей сливы, нескользящая ткань для тафтинга
aliexpress.ru
$5.08
Wallet Glitter Magnetic Suction Leather Case For iPhone 15 15 Plus 14 Pro 13 Pro Max 12 Mini 11 Pro XS XR SE 2022 8 7 6 Plus 5
aliexpress.ru
$4.74
Anime Demon Slayer Mouse Pad Gamer Gaming Custom New MousePads keyboard pad Natural Rubber Anti-slip Office Gamer Laptop
aliexpress.com
$7.38
That's What I Do I Drink Coffee I Hate People And I Know Things Drinking O Neck TShirt Bear Pure Cotton Basic T Shirt Girl
aliexpress.com
$55.10
Custom LOGO Car Floor Mats for Dodge Charger All model Charger RT SRT auto Carpets rug carpet accessories styling interior parts
aliexpress.com
$89.60
Stainless Steel Lab Vortex Mixer with Different Optional Tube Adapters Vortex-2 Vortex-1
aliexpress.com
$24.66
AUTOOL OBD2 Cable Connector Universal 30cm Car OBD 2 Adapter OBDII Male to Female Extension Cord 16pin Extension cord
aliexpress.com
$2.70
1pcs Plastic Puppy Pet drinkers Automatic Water Feeder Dispenser Food Dish Bowl Pet Dog Cat Drinking Water For Pet Dog Cat
aliexpress.com
$6.87
12Pcs Table Football Replacement Balls Spare For 36Mm Colored Foosball Table Football Game For Adults And Children
aliexpress.com
$169.00
Purple Black Girls Plus Size Prom Dresses 2022 O Neck Crystal Long Sleeves Cocktail Gowns Homecoming Robe De Soiree
aliexpress.com
$2.89
Simple Clip Pins Earrings Jewelry Womens Girl Fashion Trendy Alloy Shaped Metal Earrings Multicolor Gifts Accessories For Ladies
aliexpress.com
$13.10
45L Large Capacity Men Army Military Tactical Backpack 3P Softback Outdoor Waterproof Bug Rucksack Hiking Camping Hunting Bags
aliexpress.com